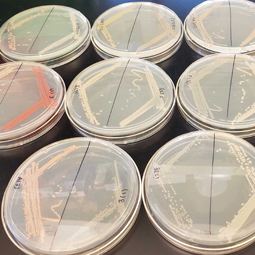

Department of Biological Sciences
- SC.edu
- Study
- Colleges and Schools
- Arts and Sciences
- Department of Biological Sciences
- Research
- Ecology & Evolution
Ecology
The Ecology group within the Department of Biological Sciences includes a strong and highly interactive faculty with national and international reputations in the fields of population, community and ecosystem ecology. The Ecology group works closely with the Evolutionary Biology group to understand the ecological context of evolutionary change and the evolutionary response to changing ecological environments. Our research programs include population dynamics, conservation biology, sensory and behavioral ecology, community ecology and evolutionary ecology. Our diverse research questions include understanding the impacts of climate change and other human-driven changes in biological systems, the function of ecosystems and their services to human populations, and the drivers and consequences of biodiversity across levels of biological organization. Our research systems range from marine to freshwater to terrestrial and include studies on birds, plants, and a wide range of invertebrates. Many of our research studies are conducted in the field from environments from all over the Earth, including the Rocky Mountains and the southwestern and southeastern United States, from the Arctic to the Antarctic, open-ocean habitats and coastal systems of the United States, Europe and Asia.